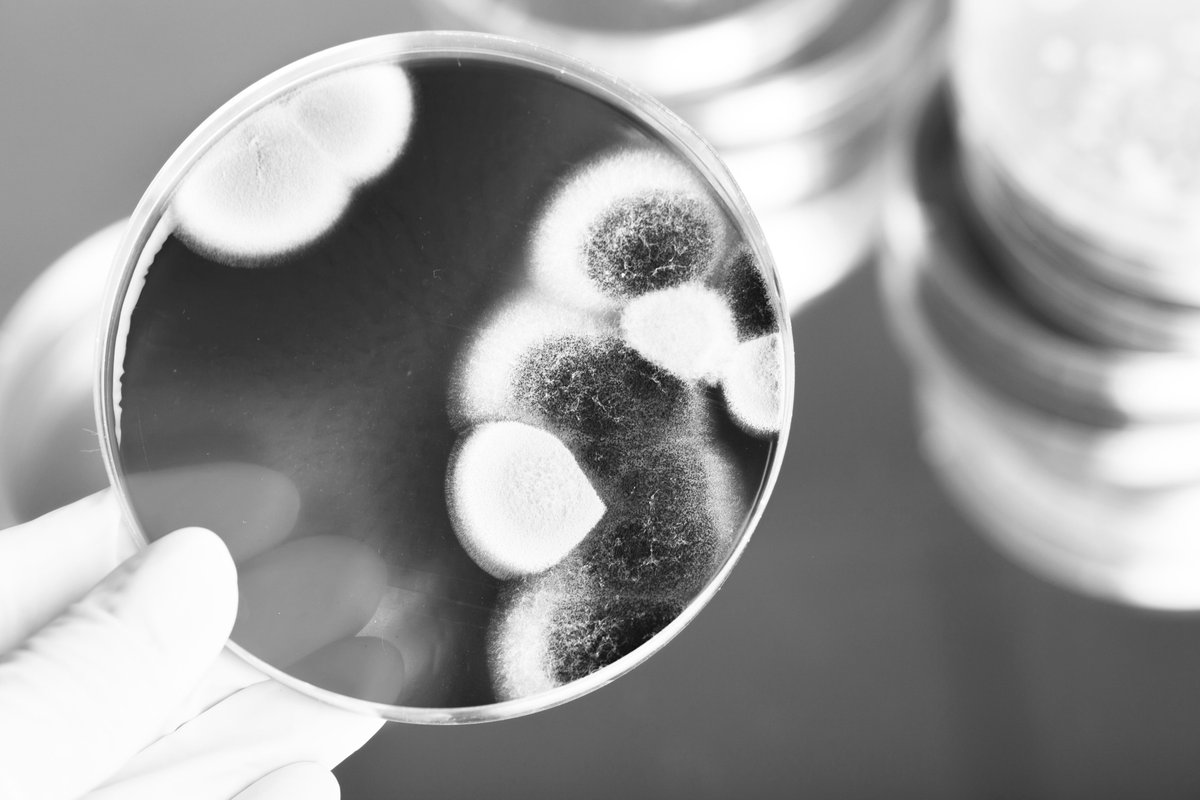
In the meantime, the UK government has still not committed to a ban on preventativeantibiotic group treatments of livestock, saying instead that it will consult with interested stakeholders on the issue. We await further details on this consultation.  #WAAW2020

It's * World Antimicrobial Awareness Week 2020 * and we want you to know that 73% of all antibiotics used worldwide are used in farmed animals. Often to prevent or treat diseases caused by poor husbandry. #WAAW2020
Antibiotics are widely used worldwide for routine disease prevention in livestock. Often antibiotics are permitted to be used for treating or preventing diseases which routinely occur as a result of poor husbandry practices, particularly in intensive farming systems. #WAAW2020
The UK is a net importer of most meat and dairy products and atm the overwhelming majority of these come from the EU. In most European countries, antibiotic use in farming is higher than in the UK, but much lower than the levels used in the US.
Luckily, the EU will ban all routine antibiotic use in farmed animals in January 2022, including all preventative group treatments. However, the UK gov has not committed to bringing in a similar ban.
https://www.saveourantibiotics.org/media/1842/2022-changes-to-european-law-farm-antibiotics.pdf
https://www.saveourantibiotics.org/media/1842/2022-changes-to-european-law-farm-antibiotics.pdf
Meanwhile, our latest report shows that total antibiotic use in US farm animals is more than 5 times higher than in UK.
https://www.saveourantibiotics.org/media/1834/farm-antibiotic-use-in-the-united-states-a-threat-to-uk-standards.pdf #WAAW2020
https://www.saveourantibiotics.org/media/1834/farm-antibiotic-use-in-the-united-states-a-threat-to-uk-standards.pdf #WAAW2020
So the trade deals on food we make with other countries, after we formally leave the EU, really matter and will have an impact on the UK farming sector as well as the food on our supermarket shelves. #WAAW2020
Read the Alliance position paper on antibiotics and trade for our recommendations on how to move forward: https://www.saveourantibiotics.org/media/1812/asoa-trade-position-paper.pdf #WAAW2020
In the meantime, the UK government has still not committed to a ban on preventative
antibiotic group treatments of livestock, saying instead that it will consult with interested stakeholders on the issue.
We await further details on this consultation. #WAAW2020
antibiotic group treatments of livestock, saying instead that it will consult with interested stakeholders on the issue.
We await further details on this consultation. #WAAW2020

 Read on Twitter
Read on Twitter